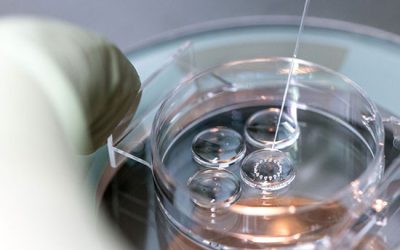
محلول کشت جنینی - شرکت دانش بنیان بافت و ژن پاسارگاد

خدمات پژوهشی جنین شناسی با روش های نوین مانند IVF
خدمات ارائه شده جنین شناسی در شرکت هیستوژنوتک
- جداسازی و شستشوی اسپرم
- اسپرموگرام با روش دستی و CASA
- رنگ آمیزی تخصصی کروماتین اسپرم
- ارائه محیط کشت های شستشو و گرادیان شیب غلظت اسپرم
- محیط دست ورزی اسپرم، تخمک و جنین
- تحریک تخمک گذاری و جداسازی فولیکول تخمدانی
- آماده سازی تخمک و انجام لقاح آزمایشی (IVF)
- تزریق داخل سیتوپلاسمی(ICSI)
- بررسی آپوپتوز در اسپرم، تخمک و جنین
- بررسی استرس اکسیداتیو در تخمدان، بیضه، اسپرم، تخمک و جنین
- بررسی میزان غلظت آنتی اکسیدان های داخل بافت و سلول
- انتقال جنین به رحم در مدل حاملگی کاذب
- فریز جنین، اسپرم و تخمک
- ارائه محیط فریز و ذوب جنین و تخمک
- آموزش تکنیک تزریق داخل سیتوپلاسمی (ICSI) در سطح بالینی
جنین شناسی و علم تولید مثل، با رشدی پرشتاب و چشمگیر، یکی از پربارترین علوم پزشکی در سه دهه اخیر به حساب می آید. تهیه و آماده سازی گامت، فراهم کردن امکان کشت، تشکیل موفق جنین در آزمایشگاه، نگهداری طولانی مدت یا انتقال صحیح آن به رحم در زمان مناسب، نمونههایی از حساسترین و ضروریترین فعالیتها در حوزه درمان ناباروری است که همگی بر یافتهها و دستاوردهای علم جنین شناسی استوار است.
به این ترتیب آزمایشگاه تحقیقاتی بافت و ژن هیستوژنوتک، آمادگی اراِئه خدمات زیر را به محققین و پژوهشگران این عرصه دارد.